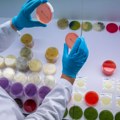
Aptamil AR1 povučen u Hrvatskoj: Tehnolog Srđan Đuričić objašnjava koliko je Bacillus cereus opasan za bebe

Srpske škole u Hrvatskoj posle 20 godina
Večernje novosti 22.06.2018 | J. Kerbler

Zagreb izlazi u susret nacionalnoj manjini. Prve na redu u Borovu, Negoslavcima i Markušici
POSLE gotovo dvadeset godina, srpske škole u Hrvatskoj, u kojima se nastava održava na srpkom jeziku i ćiriličnom pismu biće registrovane kao škole srpske nacionalne manjine. Dug je bio put do toga, a prve na redu su škole u Vukovarsko-sremskoj županiji u opštinama Borovo, Negoslavci i Markušica. Pročitajte još: Vučić i Žigmanov: Građani Srbije treba da poštuju hrvatsku zajednicu Sve do sada hrvatski državni organi izbegavali su registraciju,